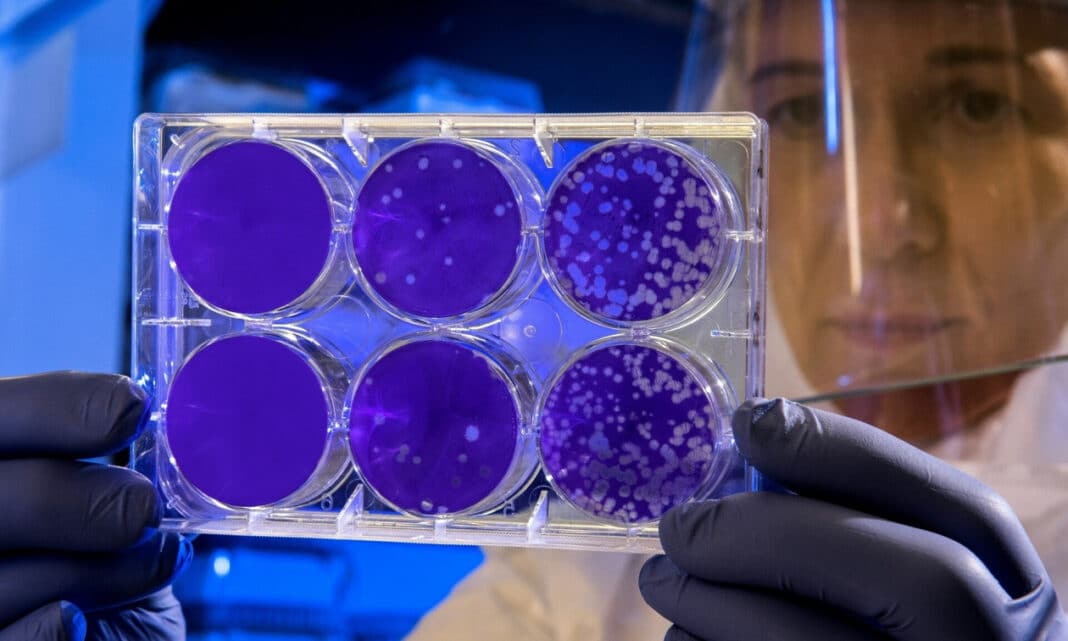

Ο χειμώνας που έρχεται και ο κίνδυνος μετάδοσης
Ένα ιικό στέλεχος που δείχνει ανησυχητική αντοχή στο ανοσοποιητικό σύστημα του ανθρώπου μπορεί, σύμφωνα με νέα έρευνα, να αποτελέσει τον πυρήνα μιας μελλοντικής πανδημίας ακόμη πιο σοβαρής από την Covid.
Επιστήμονες του Πανεπιστημίου του Κέιμπριτζ διαπιστώνουν ότι ο φυσικός θερμικός αμυντικός μηχανισμός του οργανισμού – ο πυρετός – ίσως δεν είναι αρκετός απέναντι σε ορισμένους τύπους της γρίπης των πτηνών.
Οι ιοί που αγαπούν τον πυρετό
Η μελέτη επικεντρώθηκε σε ιούς που εντοπίζονται στο κατώτερο αναπνευστικό σύστημα των πτηνών και εξετάζει πώς αυτοί μπορούν να επηρεάσουν τον άνθρωπο.
Παρότι ο οργανισμός μας επιχειρεί να καταπολεμήσει τον ιό αυξάνοντας τη θερμοκρασία του σώματος, οι επιστήμονες ανακάλυψαν ότι συγκεκριμένα στελέχη της γρίπης των πτηνών όχι μόνο αντέχουν τον πυρετό, αλλά πολλαπλασιάζονται πιο αποτελεσματικά σε αυτό το περιβάλλον.
Τι λένε οι ειδικοί
Ο μοριακός ιολόγος Δρ Σαμ Γουίλσον, επικεφαλής της έρευνας, τονίζει πως «οι άνθρωποι δεν μολύνονται συχνά από ιούς της γρίπης των πτηνών, ωστόσο καταγράφονται δεκάδες κρούσματα κάθε χρόνο» και υπενθυμίζει ότι «η θνησιμότητα σε ιστορικές λοιμώξεις H5N1 ξεπέρασε το 40%».
Σύμφωνα με τον ίδιο, η κατανόηση του μηχανισμού με τον οποίο τα πτηνά μεταδίδουν στελέχη υψηλής παθογονικότητας είναι κρίσιμη για την παγκόσμια ετοιμότητα.
Η έρευνα, που δημοσιεύθηκε στο Science, περιγράφει πώς οι επιστήμονες τροποποίησαν τα γονίδια PB1 – τα γονίδια που βοηθούν τον ιό να αναπαραχθεί – ώστε να μοιάζουν περισσότερο με τα αντίστοιχα που συναντώνται στη γρίπη Α, την πιο κοινή μορφή της γρίπης που προσβάλλει τον άνθρωπο.
Όπως σημειώνεται, η ανθεκτικότητα του «πτηνογενούς» PB1 στη θερμότητα ενδέχεται να εξηγεί γιατί ιοί που περνούν από τα πτηνά στον άνθρωπο μπορούν να προκαλέσουν πιο σοβαρή νόσο.
Ο χειμώνας που έρχεται και ο κίνδυνος μετάδοσης
Ο Δρ Ματ Τέρνμπουλ από το Πανεπιστήμιο της Γλασκόβης επισημαίνει ότι «ο εντοπισμός στελεχών που είναι πιθανό να αντέξουν στον πυρετό μπορεί να βοηθήσει στον εντοπισμό πιο επικίνδυνων μορφών του ιού».
Παρά τις διαβεβαιώσεις του CDC ότι ο κίνδυνος μετάδοσης της γρίπης των πτηνών στον άνθρωπο παραμένει «χαμηλός», η έναρξη του φθινοπώρου αυξάνει την πιθανότητα μετάδοσης. Οι ειδικοί καλούν το κοινό να παραμείνει σε εγρήγορση, ώστε να αποφευχθεί ένα ξέσπασμα παρόμοιο με εκείνο της πανδημίας του 2020.